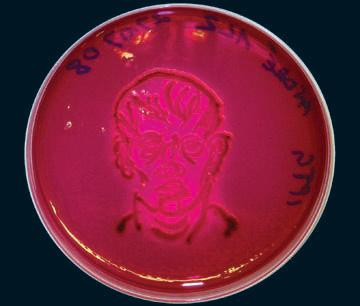

观点 SLANT
科学博物馆(Science Gallery)位于都柏林圣三一学院(Trinity College Dublin)的诺顿研究所,2011年1月28日至2月25日在该处举办了大型新媒体艺术展《肺腑之界:现场艺术实验》(VISCERAL:The Living Art Experiment)(策展人:ORON CARRS 与IONAT ZURR)。由西澳大利亚大学的SymbioticA实验室组织的这次展览围绕生命与无生命的本质问题展开追问,探索了艺术与生物科学相结合的各种可能的方式。本期媒体栏目试图通过对这次展览上作品的介绍引起关于艺术介入科学的具体途径的思考。

策展前言
在二十世纪的最后十年,人类中心论对生命形态的介入已经进入到小至分子、大至生态圈的各个层面。 生命受到人类行为的操纵和影响至深的现状,需要新的文化策略予以反思,从而考量这种介入对于生命本身意味着什么。正是带着这样的问题,SymbioticA作为一家艺术性研究机构,于2000年在澳大利亚西澳大学的解剖学与人类生物学学院正式落成。在过去的十年中,SymbioticA促成了一系列富有创意的项目,这其中包括驻留、研究、学术课程、展览、研讨会、研习班和工作坊。此次名为VISCERAL的展览不仅是一次现场实验,同时也是对SymbioticA十年来部分研究项目发展状况的历史性回顾。
从侵入“DNA指纹图谱”,运用培植神经元为计算装置以制造文化偶像,到将西澳大利亚干枯湖泊形象叠加在都柏林三一学院的地面上;VISCERAL展见证了SymbioticA以其广泛的艺术干预和实验探索人类对于生命操纵(问题)的关注。此次VISCERAL展被设计为一个实验现场,期间,SymbioticA实验室被移植到科学博物馆,针对数个项目的研究和实验将在展览期间持续上演。通过这样的形式,使干预生命体这一过程成为可参与的,从而带来发自肺腑的真挚体验,同时,更能够将所有的参与者,包括普通观众,带入到一个更大的以技术和科学手段对待生命问题的当代视野之中。VISCERAL所展示的艺术探索的核心,在于人类对于生命过程的干预需在文化层面上做出解读。与其说是以先入为主或说教的态度来看待生命现象,VISCERAL展则特意以一种模糊的姿态,为关于未来“生命”的探讨、批评和讨论提供空间,无论这种“生命”是物质的、实体的,或一种概念。
作品介绍

1. 辉煌幻象 The Vision Splendid
艺术家:Alicia King,澳大利亚
“The Vision Splendid”旨在以雕塑的形式来强化人体组织以探讨生物技术,以及在物理、伦理和礼仪意义中的“身体”这一概念。这件作品中,存活在玻璃制的生物反应器中的活体组织取自一位匿名的女性病患。这些细胞(于1969年1月31日剥离自一个13岁美籍非裔女性的皮肤样本)是从美国模式菌种收集中心(ATCC)的网上目录中购买的。在这个在线目录中,有超过4000份人体、动物和植物的细胞系以供出售。若要从ATCC目录的数千个条目中寻找到所需的细胞,则需要专注而耐心从网上的各式讣告中搜寻。在这件作品中,细胞组织已经发生了意义上的异化,从捐献者身体的一部分转而成为一件当代的活体舍利。这件活着的遗骸,一个真正的辉煌幻象,同时也是生物科技的一件制品,它的意义是使得终极的奇迹在眼前上演。这个奇迹便是死亡发出的悲泣,抑或是“造物者”本源力量的显现,又或者,是ATCC,是机构本身。正如供呈在斯巴达的蛋,被认定是丽达与天鹅结合的真实遗迹一样,这件活着的遗骸,也是生物科技发展成果的确证。

2. 来世:KIRA和RAMA的不朽 Afterlife: Immortalization of Kira and Rama
艺术家:Svenja Johni Kratz, 澳大利亚
“来世:KIRA和RAMA的不朽”的灵感来自于对生与死理解的转换,以及自我与他者的相互关系,是对当代的生物科技发展的特定现象的回应。这件作品包括一个定制的带有强烈埃及风格暗示的生物反应器,反应器中装载着用慢病毒质粒(即细菌的DNA分子中包含病毒性载体)进行了防腐处理的胎牛细胞,此外还有同样经过处理的从胎牛身体上取得的心脏、皮和骨骼碎片。这件作品着眼于探讨伦理的模糊性以及随着人类利用及操纵生物体而带来的挑战,尤其针对细胞和组织培植中胎牛血清(FBS)的使用。胎牛血清是一种从胎牛血液中提取的富含蛋白质的血清,常常在培植细胞时作为营养补充物以帮助细胞存活时使用。这件作品特别强调了这样一个问题,即在消费链的每一个层级上都会有受害者,而划分伤害的造成、利益的产生两者之间的界限往往游移不定、模糊不清。这件展品,同时也是将在展览中持续进行的项目,由SymbioticA 研究小组, Svenja Kratz, Dusty Tame 和John Barnard共同合作完成。
3. 20次方的原始活力 Proto-animate20
艺术家:Andre Brodyk, 澳大利亚
是否能够通过现代生物技术的处理使不具编码条件的DNA获得新生呢?Proto-animate所关注的问题是在基因体环境中,由于不进行蛋白编码从而被认为属于非活性的基因物质。然而这些非编码线段确具有尚未界定的潜在属性。 在 Proto-animate20中,一种新颖的编码由158个DNA 字母(基数)构成,这些DNA字母来自通常被认为是基因的非编码域。称为APOE(Apolipoprotein) 的这种基因和老年痴呆症有关联。该基因序列被植入E.coli 细菌,是起主要作用的媒介。这个过程使一个先前没有生命的,不具编码条件的 DNA 片段得以在记忆和重复中获得诗意的表达。
是否能够通过现代生物技术的处理使不具编码条件的DNA获得新生呢?Proto-animate所关注是在基因组中由于不编码蛋白而被认为没有活性的遗传物质。然而这些非编码DNA 链具有尚未界定的潜在属性。 在 Proto-animate20中,一个新的DNA序列由158个DNA 字母(碱基)构成,这段DNA序列来自通常认为的非编码域。称为APOE(Apolipoprotein E) 的这种基因着和老年痴呆症有关联。该基因序列被插入E.coli 细菌 (大肠杆菌),使其成为主要的媒介。这个过程使一个先前没有生命的,不具编码条件的 DNA序列得以在记忆和重复的相互作用中得以的表达。

4. The SemiLiving Worry Dolls 半存活分忧玩偶
艺术家:Oron Catts and Ionat Zurr, 澳大利亚
十一年前,“分忧玩偶”是出现在画廊中的第一件活体组织雕塑作品。作品的灵感来自危地马拉的一种玩偶:分忧玩偶,孩子们可将自己的烦恼告诉分忧玩偶 ,而玩偶将会帮孩子们解除烦恼。作品中的分忧玩偶是用可降解聚合物(PGA和P4HB)经手工缝合制成。置入微重力生物反应器当中,同时在降解物之中植入活体细胞,这些细胞在整个展览过程中不断生长,并逐渐取代聚合物成为 分忧玩偶的身体。由此,分忧玩偶成为具有部分生命的玩偶。这些半存活状态的玩偶反映出当下的一种文化困境,即面对科技,人类所表现出的如同稚童一般的无知,同时怀揣着混杂着憧憬与畏惧的复杂心情。不若也把这份隐忧向分忧玩偶低声倾诉——而它们真的能带走我们的烦恼吗?

5. CRYOBOOK档案
艺术家:Tagny Duff, 加拿大
这件装置的主角是一系列手工书本,这些书本由人和猪的外植组织、人永生化表皮细胞以及生物合成病毒(慢病毒)制成。这些“皮肉书”的制作将组织培植技术,例如转染和免疫组化染色技术,以及传统的书籍装订技艺结合在了一起。四件作品被放置在一个可移动式冰箱中展出,并被命名为“CRYOBOOK档案”,冰箱也由此成为一个微型图书馆。这件作品的设计由Tagny Duff, John Greyson和Vincent Chavalier共同完成,David St.Onge, Benoit Allen 和Jean-Michel Dussault提供技术支持。

6. Blood Wars 血液战争
艺术家:Kathy High, 美国
血液战争是一个着眼于人体白血球细胞的生物学反应,并质疑血液遗传性状这一问题的艺术项目。血液战争设立了一种模拟的竞赛,即来自不同人的白血球细胞共同争夺在培养皿中的主控地位。血液战争以游戏的方式介入到一场历史久远的关于血液特性的争论当中,同时介入到有关血的历史的讨论中。白血球细胞之间的竞争机制是两两对决,而每轮的胜出者会进入到下一场,比拼另一位“竞争者”。通过这个项目,我们将会更进一步了解血细胞分裂,透过细胞膜的液体交换,免疫系统以及血液疾病的继承性谜题等问题。
